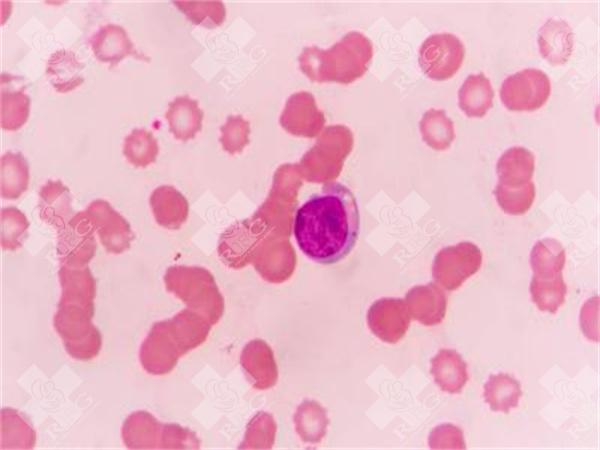
试管调理方法有哪些?试管前如何调理身体可以提高成功率!

发布时间:2024-03-17 16:34:59
柬埔寨皇家生殖遗传医院(RFG)
试管婴儿技术为许多不孕不育夫妇带来了生育的希望。然而,成功率的提高与众多因素有关,其中身体调理是非常关键的一环。本文将探讨试管前的调理方法,帮助准备进行试管婴儿的夫妇提高成功率。
在进行试管婴儿前,夫妇双方都需要进行身体调理,以提高成功率。调理方法主要包括以下几个方面:
调整生活方式:包括保持规律的作息、避免熬夜、适度运动、保持良好的饮食习惯等。这些都有助于提高身体素质,为试管婴儿的成功打下基础。
心理调适:试管婴儿过程中,夫妇可能会面临一定的心理压力。因此,进行适当的心理调适,如放松训练、冥想等,有助于缓解压力,提高成功率。
药物治疗:根据医生的建议,可能需要进行一些药物治疗,如激素调整、改善卵子质量的药物等。这些药物的使用需要在医生的指导下进行,以确保安全和有效。
在进行试管婴儿前,夫妇双方可以采取以下措施调理身体,以提高成功率:
均衡饮食:保持营养均衡的饮食,摄入足够的蛋白质、维生素和矿物质。同时,增加抗氧化食物的摄入,如水果、蔬菜等,有助于提高卵子和精子的质量。
适度运动:进行适度的有氧运动,如散步、瑜伽等。运动有助于提高身体素质,改善卵子和精子的质量,同时也有助于缓解心理压力。
避免不良生活习惯:戒烟、戒酒、避免过度劳累和不良环境。这些不良生活习惯可能对卵子和精子的质量产生负面影响,进而影响成功率。
保持积极心态:保持积极乐观的心态,避免过度焦虑和紧张。可以尝试进行心理调适,如冥想、放松训练等,以缓解压力,提高成功率。
上一篇: 亳州涡阳县试管婴儿可以做吗?
上一篇: 如何调节试管怀孕?怎样做试管婴儿调理好?
返回列表
推荐阅读
阜阳私立机构试管第二代成功率高吗,3个方法成功率翻倍
阜阳的私立医疗机构在辅助生殖技术方面,尤其是试管婴儿技术上,近年来确实有越来越多的人选择。对于“试管第二代成功率高吗”这个问题,很多人其实并不太清楚二代试管到底是什么,更关心的是成功率如何,以及有没有...
2025-11-17 15:32:04
查看全部
天水私立机构正常女性做试管婴儿成功率解析,附提高成功率技巧
在天水,越来越多的女性因为各种原因选择通过试管婴儿来实现生育梦想。相比公立医院,私立机构在服务、环境、个性化方案上可能更有优势,但大家最关心的还是成功率和如何提高成功率。开展人类辅助生殖技术的医疗机构...
2025-11-17 13:52:21
查看全部
羊水穿刺正常仍生下畸形儿的概率高吗?
羊水穿刺是一种常见的产前检查方式,主要用于检测胎儿是否存在染色体异常,比如唐氏综合征、爱德华氏综合征等。这项检查通过抽取孕妇的羊水样本,对里面的胎儿细胞进行分析,准确性相对较高。但即便如此,也不能百分...
2025-11-16 23:46:35
查看全部
女生不结婚在国内能做试管生个孩子吗?
在国内,未婚女性想要通过试管婴儿技术生育孩子,目前在法律和实际操作上都存在一定的限制。试管婴儿技术,也就是体外受精(IVF),主要是帮助那些因为身体原因无法自然受孕的夫妻。这项技术原本是为了解决不孕不...
2025-11-16 20:29:24
查看全部
酒泉私立机构试管婴儿空卵泡怎么办,解决方案及成功率分享
如果你在酒泉做试管婴儿时遇到“空卵泡”的问题,心里肯定挺着急的。空卵泡,说白了就是医生卵泡取出的时候发现卵泡里没有卵子,这种情况虽然不常见,但确实会让人很沮丧。尤其是当你已经做了促排、打了很多针,结果却空...
2025-11-16 13:53:42
查看全部
仙桃私立机构年龄大做试管几代成功率高,123代试管成功率对比
在仙桃,一些年纪偏大的女性如果自然怀孕困难,可能会考虑通过试管婴儿的方式来实现生育。尤其是私立机构,因为服务更个性化,很多人也会选择去那里做试管。但大家最关心的问题就是:做几代试管成功率高?特别是像第...
2025-11-16 07:16:23
查看全部
陈仓私立机构子宫纵隔试管成功率有多大,专业医生为您解答
关于“陈仓私立机构子宫纵隔试管成功率有多大”这个问题,很多朋友可能都在网上看到过一些信息,但又觉得不太确定,心里没底。其实,很多人在做试管婴儿之前都会遇到这样的困惑,特别是对成功率这块儿特别关心。咱们...
2025-11-16 03:59:09
查看全部
湘西宁儿医院做试管婴儿好吗,湘西宁儿生殖医院开业了没有
湘西宁儿医院这个名字听起来可能和湘西地区的某个医疗机构有关,但目前公开的信息中,并没有特别多关于“湘西宁儿医院”或者“湘西宁儿生殖医院”的详细资料。如果你是在打听这家医院是不是已经开业,或者它在试管婴...
2025-11-15 23:47:41
查看全部
上海试管医院哪里做比较好 上海试管婴儿哪家医院成功率高
在上海做试管婴儿,很多夫妻都会考虑去一些口碑好、成功率高的医院。毕竟这事儿关系到家庭幸福,选对医院特别重要。下面我给你说说上海几家在这方面比较有名的医院,供你参考。开展人类辅助生殖技术的医疗机构医院名...
2025-11-15 18:50:07
查看全部
咨询热线
4000279913
微信客服
在线留言
返回顶部